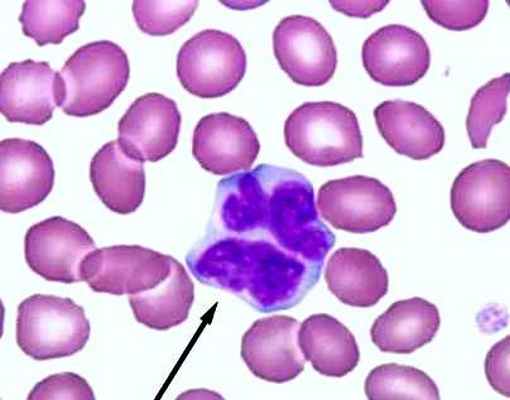
причины лимфомы Беркитта

Эндемическая лимфома Беркитта. Спорадическая лимфома Беркитта.
Добавил пользователь Евгений Кузнецов Обновлено: 02.11.2025
Лимфома Беркитта (ЛБ) – злокачественная опухоль из группы неходжкинских лимфом, образующаяся из зрелых В-лимфоцитов. Характеризуется повышенной агрессивностью, высокой пролиферативной активностью, коротким анамнезом (несколько недель) и склонностью к рецидивам. Обычно рецидивы развиваются в течение 6-9 месяцев после окончания курса химиотерапии, позже встречаются крайне редко.
Согласно МКБ-10 лимфоме Беркитта соответствует код 2A85.6.
В зависимости от причины болезни различают 3 типа ЛБ:
Спорадическая. Встречается в неэндемической зоне.
ВИЧ-ассоциированная. Развивается на фоне иммунодефицитных состояний (у ВИЧ-инфицированных людей, в основном у мужчин.
Для патогенеза ЛБ характерно усиление экспрессии протоонкогена c-MYC.
Чаще всего опухоль локализуется в брюшной полости, крайне редко – в средостении.
Симптомы
Для опухоли характерны В-симптомы: фебрильная лихорадка, выраженная потливость, быстрая потеря веса (до 10 килограмм в месяц), истощение (вплоть до кахексии). Часто появляются боли разной интенсивности в эпигастральной области, увеличиваются лимфоузлы, развивается почечная недостаточность, что приводит к электролитным нарушениям. Больной может жаловаться на невозможность самостоятельного мочеиспускания.
Опухоль быстро растет, вызывая интоксикацию и истощение организма, из-за чего больные обычно попадают в клинику в тяжелом или очень тяжелом состоянии (на 3-4 стадии).
При лимфоме Беркитта симптомы зависят от типа, объема и расположения опухоли.
Эндемическая лимфома чаще всего затрагивает лицевую область. В результате расширяются альвеолы, выпадают и смещаются зубы, обнаруживаются дефекты надкостницы. Возможно поражение органов брюшной полости (в 40-55% случаев), ЦНС (в 30% случаев), половых желез (редко).
Спорадическая лимфома поражает желудочно-кишечный тракт, захватывает половые железы и лимфоузлы, иногда (в 20-35% случаев) – костный мозг. У больного быстро увеличивается в размерах живот вследствие роста опухоли и развития асцита, возможны желудочно-кишечные кровотечения, кишечная непроходимость.
Диагностика
Большинство больных попадают к врачу с ярко выраженной симптоматикой, благодаря чему удается диагностировать ЛБ на основании изучения анамнеза и физикального осмотра.
Чтобы подтвердить диагноз, доктор направляет пациента на обследование:
клинический и биохимический анализ крови;
— исследование крови на группу и резус-фактор:
— общий анализ мочи;
— биохимию крови и мочи;
— исследование крови на ВИЧ-инфекцию, гепатит, сифилис;
— УЗИ брюшной полости;
— компьютерную томографию и ПЭТ-КТ;
— биопсию с дальнейшим цитологическим и гистологическим анализом;
— трепанобиопсию костного мозга
При поражении желудочно-кишечного тракта делают колоноскопию или фиброгастродуоденоскопию, а при наличии асцита или плеврита – лапароцентез или плевральную пункцию Женщинам детородного возраста рекомендован тест на беременность.
При необходимости направляют на консультацию к другим специалистам (нефрологу, урологу, гинекологу, офтальмологу, отоларингологу, невропатологу).
В случае рецидива или прогрессирования болезни проводят повторную биопсию.
Прогноз
ВИЧ-позитивные пациенты с ЛБ при получении параллельно антиретровирусной терапии могут иметь сопоставимые результаты с больными без иммунодефицита.
Лечение
Основным методом лечения ЛБ являются интенсивные режимы ПХТ. Дополнительно назначают симптоматическое лечение, чтобы откорректировать электролитные нарушения и устранить другие симптомы. При острой почечной недостаточности ежедневно проводят сеансы гемодиализа.
Хирургическое лечение лимфомы Беркетта нецелесообразно. Оно не только не улучшает состояние, но и приводит к потере времени и ухудшению прогноза из-за продолжительной реабилитации после операции и быстрого повторного роста опухоли.
Хирургическое вмешательство оправдано только при угрожающих жизни состояниях (желудочно-кишечных кровотечениях, перфорации органов, кишечной непроходимости
Заполните всего три поля
и наш специалист Вам перезвонит!
Ваши данные успешно отправлены! Ожидайте нашего звонка.
РАДИОХИРУРГИЯ КИБЕРНОЖ
Инновационный метод лечения,
радиохирургия на системе
"КиберНож" , применяется в
Клинике Спиженко для
дистанционного лечения
опухолей
ЛУЧЕВАЯ ТЕРАПИЯ IMRT
Лучевая терапия опухолей
в Клинике Спиженко
проводится на линейном
ускорителе последнего
поколения Elekta с
функцией IMRT
(максимальной защиты
здоровых тканей)
МАЛОТРАВМАТИЧНАЯ ХИРУРГИЯ - ЛАПАРОСКОПИЯ
Современные методы хирургического лечения онкологических пациентов применяются в Центре
хирургии Клиники Спиженко на постоянной основе, в том числе, малотравматичая лапароскопия
Лимфома Беркитта
Лимфома Беркитта — злокачественная опухоль из лимфоидной ткани, агрессивная разновидность неходжкинской лимфомы. При этом заболевании в организме образуются аномальные .


По разным данным, лимфома Беркитта составляет от 0,3 до 5% всех неходжкинских лимфом у взрослых, а у детей — до 30%. Чаще всего ее диагностируют в возрасте 5–10 лет. Заболеваемость среди детей младше 18 лет составляет 3–6 случаев на 100 000. Среди взрослых пациентов большинству 30–50 лет. Мужчины болеют 3–4 раза чаще по сравнению с женщинами.
Для лимфомы Беркитта характерно весьма агрессивное течение, она склонна распространяться в центральную нервную систему. Поэтому лечение нужно начинать как можно раньше после установления диагноза. В Международной клинике Медика24 доступны все виды современной онкологической помощи.
Причины развития, факторы риска
В зависимости от причин развития заболевания, эксперты Всемирной Организации Здравоохранения (ВОЗ) выделяют три разновидности лимфомы Беркитта:
- Лимфома Беркитта, связанная с иммунодефицитными состояниями, диагностируется у людей, страдающих СПИДом или принимающих препараты, подавляющие иммунитет, после трансплантации органов.
- Спорадическая лимфома Беркитта — наиболее распространенная форма заболевания в западных странах. Она связана с вирусом , который вызывает инфекционный мононуклеоз. Люди, перенесшие эту инфекцию, имеют повышенный риск развития лимфомы Беркитта. Тем не менее, вероятность ее развития даже в этой группе остается низкой. Далеко не у всех людей, переболевших инфекционным мононуклеозом, развивается лимфома.
- Эндемическая лимфома Беркитта встречается наиболее часто. Это одна из самых распространенных злокачественных опухолей у детей. Но в западных странах эту форму заболевания диагностируют редко — она в основном распространена в Африке. В ходе научных исследований были получены данные о том, что эндемическая лимфома Беркитта связана с малярией и вирусом .
Обычно в клетках лимфомы Беркитта имеются изменения в восьмой хромосоме, затрагивающие ген MYC. Он кодирует одноименный белок Myc, относящийся к факторам транскрипции. Этот белок контролирует синтез РНК на матрице ДНК — первый этап синтеза белка, и влияет на многие аспекты клеточного деления. В результате нарушения ген MYC становится постоянно активным, и клетки начинают бесконтрольно размножаться. Это происходит при транслокации — когда восьмая хромосома обменивается участками с 14, 2 или 22 хромосомой.
Анализ на мутацию в гене Myc — важная составляющая обследования при подозрении на лимфому Беркитта. Он помогает установить точный диагноз. В клинике Медицина 27/4 выполняются все необходимые генетические исследования.
Закажите обратный звонок. Мы работаем круглосуточно
Симптомы заболевания
Проявления лимфомы Беркитта зависят от того, где она находится. Опухоль может локализоваться как в лимфатических узлах, так и в различных органах, в которых имеется лимфоидная ткань (экстранодальные поражения). Для лимфомы Беркитта более характерна экстранодальная локализация. Наиболее распространенные проявления формы заболевания, связанной с иммунодефицитом:
- При поражении подкожных лимфатических узлов появляется опухоль, которую можно увидеть и прощупать. Обычно она безболезненная и быстро растет.
- При лимфомах в брюшной полости беспокоит дискомфорт, боль в животе, тошнота, увеличение живота, боли в спине, диарея. Могут возникнуть симптомы кишечной непроходимости, кровотечения.
- При лимфомах красного костного мозга опухолевые клетки вытесняют нормальную кроветворную ткань. В итоге снижается количество всех клеток крови. Чаще всего таких пациентов беспокоит одышка, постоянное чувство усталости, повышенная кровоточивость, которая проявляется в виде синяков.
- Общие симптомы включают потерю веса (до 10 кг и более за месяц), беспричинные повышения температуры тела, потливость по ночам, зуд во всем теле. Эти проявления называются .
Спорадические лимфомы Беркитта чаще всего находятся в брюшной полости, реже в области головы, шеи. В редких случаях отмечается поражение челюсти, красного костного мозга, средостения, центральной нервной системы, яичек, кожи, щитовидной железы и молочной железы.
Эндемическая форма обычно проявляется в виде поражения челюсти, мочеполовой системы или отека вокруг глаз.
Симптомы лимфомы Беркитта могут появиться и сильно нарасти в течение всего нескольких дней. В Международной клинике Медика24 в любое время можно получить помощь, максимально быстро начать лечение.
Методы диагностики лимфомы Беркитта
После того как диагноз подтвержден, нужно уточнить, насколько сильно злокачественная опухоль распространилась в организме. Обычно в первую очередь выполняют компьютерную томографию брюшной полости, грудной клетки и таза. Затем проводят более информативное исследование ПЭТ/КТ. Во время него в организм пациента вводят специальный безопасный радиофармпрепарат, который накапливается в опухолевых очагах и делает их видимыми на снимках.
Выполняют биопсию красного костного мозга, исследование спинномозговой жидкости, которую получают во время люмбальной пункции. Также обследование включает анализ крови на уровень лактатдегидрогеназы (ЛДГ), мочевой кислоты, общий анализ крови, определение СОЭ, протромбинового времени, анализ на .
Стадии
Для определения стадии лимфомы Беркитта применяется система Мерфи (Murphy S.B.):
I стадия
Один опухолевый очаг в лимфатическом узле или экстранодальной локализации, кроме брюшной полости, средостения и центральной нервной системы.
II стадия
- Один экстранодальный очаг, распространившийся в регионарные лимфатические узлы.
- Поражены разные группы лимфоузлов, которые находятся либо только выше, либо только ниже диафрагмы.
- Два экстранодальных очага по одну сторону от диафрагмы. Опухоль может распространяться в регионарные лимфатические узлы.
- Первичная опухоль в области слепой кишки.
Как и при I стадии, нет очагов в брюшной полости, средостении и центральной нервной системе.
IIR
Лимфома, которая была полностью удалена во время операции.
IINR
Опухоль удалена не полностью.
III стадия
- Два экстранодальных очага, расположенных по разные стороны от диафрагмы.
- Опухоли в двух или большем числе групп лимфоузлов по разные стороны от диафрагмы.
- Первичная опухоль в брюшной полости, средостении или центральной нервной системе.
IV стадия
Опухоль любой локализации, которая распространилась в красный костный мозг, центральную нервную систему, либо имеется много очагов в скелете.
Лечение лимфомы Беркитта
Лечение важно начинать максимально оперативно, потому что лимфома Беркитта очень быстро растет. В Международной клинике Медика24 для этого есть всё необходимое. При своевременной и правильной терапии полностью излечиваются 80% детей и взрослых младше 60 лет.
Основной метод лечения лимфомы Беркитта — интенсивная химиотерапия. Она продолжается в течение нескольких месяцев, и пациент очень много времени проводит в клинике. Применяются разные комбинации химиопрепаратов:
- R-CODOX-M: ритуксимаб + циклофосфамид + винкристин + доксорубицин + метотрексат.
- R-IVAC: ритуксимаб + ифосфамид + этопозид + цитарабин.
- R-CHOP: ритуксимаб + циклофосфамид + доксорубицин + винкристин + преднизолон.
- DA-EPOCH-R: ритуксимаб + этопозид + преднизолон + винкристин + циклофосфамид + доксорубицин.
Некоторые виды лимфомы Беркитта с высокой вероятностью распространяются в центральную нервную систему. В таких случаях в целях профилактики применяют химиопрепарат метотрексат. Его вводят интратекально — в пространство, окружающее спинной мозг, или внутривенно в высоких дозировках.
На фоне химиотерапии может возникнуть синдром распада опухоли — опасное состояние, при котором вещества, выделяющиеся в результате разрушения опухолевых клеток, поступают в кровоток и приводят к отравлению организма. Это грозит тяжелым нарушением функции почек, судорогами, сердечной аритмией. В Международной клинике Медика24 применяются все необходимые препараты, чтобы предотвратить и быстро купировать это состояние.
Мы вам перезвоним
Хирургическое лечение при лимфомах Беркитта применяется нечасто. Как правило, к операции прибегают, когда большая опухоль сдавливает органы, приводит к их непроходимости, мучительным болям.
Лучевую терапию также применяют для борьбы с симптомами, вызванными сдавлением органов, а также перед трансплантацией стволовых клеток.
Прогноз выживаемости
Прогноз при лимфоме Беркитта зависит от стадии заболевания и некоторых других факторов. Более молодые пациенты и дети лучше переносят курсы химиотерапии, и у них чаще наступает ремиссия.
К неблагоприятным относят следующие прогностические факторы:
- старший возраст;
- слабый ответ на противоопухолевые препараты;
- поражение центральной нервной системы;
- значительное повышение уровня лактатдегидрогеназы в крови;
- генетические нарушения в клетках, помимо изменения в MYC;
- низкий уровень при лимфоме Беркитта, связанной с иммунодефицитными состояниями;
- рецидив в течение 6 месяцев после завершения лечения.
На какой бы стадии ни было диагностировано заболевание, и как бы оно ни протекало — пациенту можно помочь, и лечение нужно начинать как можно быстрее. В Международной клинике Медика24 работают ведущие врачи, оказываются все необходимые виды помощи, применяются противоопухолевые препараты последних поколений.
Лимфома Беркитта

Лимфома Беркитта является агрессивной В-клеточной лимфомой, возникающей у детей и взрослых. Выделяют эндемическую (африканскую), спорадическую (неафриканскую) и связанную с иммунодефицитом формы.
Классическая лимфома Беркитта эндемична в Центральной Африке и составляет 30% лимфом у детей в США. Эндемичная форма, как правило, манифестирует увеличением нижней челюсти и костей лицевого черепа.
При спорадической лимфоме Беркитта чаще поражаются внутрибрюшные лимфоузлы, в основном в области брыжейки тонкой кишки и илеоцекальной складки. Опухоль может вызывать кишечную непроходимость. Также могут поражаться экстранодальные участки, такие как мозг или другие паренхиматозные органы. У взрослых заболевание может иметь обширный и генерализованный характер, часто с массивным поражением печени, селезенки и костного мозга. При диагностировании или рецидиве лимфомы часто уже имеется поражение центральной нервной системы (ЦНС).
Лимфома Беркитта является наиболее быстро растущей опухолью человека; при патоморфологическом исследовании определяется высокая пролиферативная активность, моноклональная пролиферация В-клеток, картина «звездного неба» – доброкачественные макрофаги, поглощающие апоптотические малигнизированные лимфоциты. На ФДГ-ПЭТ (фтордезоксиглюкоза-позитронной эмиссионной томографии) опухоли проявляются высоко метаболичными. Характерно наличие транслокации гена C-myc на 8 хромосоме и тяжелой цепи иммуноглобулина на 14 хромосоме. Эндемическая форма заболевания тесно связана с вирусом Эпштейна – Барр Инфекционный мононуклеоз Инфекционный мононуклеоз вызывается вирусом Эпштейна – Барр (ЭБВ, герпесвирус человека тип 4), проявлениями заболевания является общая слабость, лихорадка, фарингит и увеличение лимфатических. Прочитайте дополнительные сведенияДиагностика лимфомы Беркитта
Биопсия лимфоузлов или костного мозга
Гистологический диагноз основывается на результатах биопсии лимфоузла или другого очага опухолевого поражения, например костного мозга. В редких случаях как для диагностики, так и для лечения необходимо выполнение лапароскопии.
Стадирование включает в себя визуализацию опухоли с помощью ФДГ-ПЭТ/КТ. В случае, если этот метод недоступен, вместо него может быть выполнена КТ грудной клетки, брюшной полости и таза. Пациентам следует также выполнить биопсию костного мозга, цитологию спинномозговой жидкости и лабораторные исследования с определением лактатдегидрогеназы (ЛДГ). В связи со стремительным ростом опухоли все обследования необходимо выполнять в максимально короткие сроки.
Лечение лимфомы Беркитта
В связи с быстрым ростом этих опухолей лечение должно быть начато в максимально короткие сроки. Применение интенсивного альтернирующего режима, включающего циклофосфамид, винкристин, доксорубицин, метотрексат, ифосфамид, этопозид и цитарабин (CODOX-M/IVAC) плюс ритуксимаб, позволяет излечить > 80% детей и взрослых
В случае удаления опухоли до начала лекарственного лечения (например, из-за развития кишечной непроходимости), проведение агрессивной химиотерапии тем не менее обязательно, однако потребуется меньше циклов. В конце лечения у пациентов должен определяться полный метаболический ответ, подтвержденный ПЭТ, или полный ответ, подтвержденный КТ, вместе с отрицательными результатами биопсии костного мозга. Результат плохой у 20% пациентов с неудачной индукционной терапией или рецидивом (как правило, в первые 12 месяцев). Следует рассмотреть возможность сальвадж-терапии или применения клинических подходов.
Дополнительная информация
Ниже приводится англоязычный ресурс, предоставляющий информацию для врачей, а также содействие и информацию для пациентов. Сервис The manual не несет ответственности за содержание этого ресурса.
Leukemia & Lymphoma Society предоставляет образовательные ресурсы для медицинских работников
Авторское право © 2022 Merck & Co., Inc., Rahway, NJ, США и ее аффилированные лица. Все права сохранены.
Лимфома Беркитта - новые методы диагностики и лечения
Лимфома Беркитта — принадлежит к группе неходжкинских лимфом. Заболевание характеризуется высокой степенью злокачественности, быстро прогрессирует. Если больному вовремя не оказать качественную медицинскую помощь, то летальный исход неизбежен.
Лимфома Беркитта: коротко о главном

Среди злокачественных заболеваний крови особую группу составляют лимфомы – поражение лимфатической ткани. Их существует множество различных видов, среди которых лимфома Беркитта относится к наиболее злокачественным. Впервые это заболевание досконально изучено английским врачом Дэнисом Беркиттом, в честь которого и получило своё название.
Лимфома Беркитта встречается в любом возрасте, протекает очень тяжело, с образованием опухолевых очагов в органах, костях и полостях тела, имеет очень высокий процент летальности в странах с невысоким уровнем медицины. Более оптимистична ситуация в цивилизованных странах, где лечение лимфомы даёт хорошие результаты, в частности, лечение в Израиле , где специалисты применяют новейшие достижения в области онкогематологии.
Почему развивается лимфома Беркитта?
Как и при всех злокачественных заболеваниях, в основе развития лимфомы Беркитта лежат мутации в генах, отвечающих за рост и созревание лимфатических клеток Т-лимфоцитов. Начинается их бесконтрольное образование, деление, а процесс вызревания клеток отстаёт. В итоге образуется множество незрелых (бластных) форм лимфоцитов, которые не только не выполняют свою функцию, но и являются токсичными, злокачественными для организма.
Такие мутирующие гены могут передаваться по наследству, а также активизироваться под воздействием вирусных инфекций (вирус Эпштейна-Барр), тяжёлых интоксикаций. Лимфома часто развивается у ВИЧ-инфицированных и больных СПИДом, может возникнуть после проведенной интенсивной химиотерапии из-за резкого снижения иммунитета.
Вирус Эпштейн-Барр — что это?

Для начала отметим, что эндемическая африканская лимфома Беркитта вызывается вирусом Эпшейна-Барр в 95% случаев.
Вирус этот весьма популярен во всем мире и входит в «семейство» вирусов герпеса. Его практически невозможно уничтожить. Заразившись однажды, человек становится переносчиком вируса на все жизнь и может заразить других людей.
По статистике, во всем мире примерно 90% населения «носят» вирус Эпштейна-Барр. Заражаются им обычно в детском возрасте. Примерно в 50% случаев дети получают его от матери в период грудного вскармливания.
Чаще всего вирус передается через поцелуи. Связано это с тем, что в области слюнных желез сосредоточена большая часть вирусных частиц. Выделяются они вместе со слюной и вызывают распространенное заболевание — инфекционный мононуклеоз (болезнь поцелуев).
Вирус Эпштейна-Барр также может передаваться следующим образом:
- переливание крови,
- воздушно-капельный путь,
- пересадка костного мозга.
Формы лимфомы Беркитта
Различают 3 формы лимфомы Беркитта:
- Эндемическая - ее вспышки возникают в определённых регионах, чаще в африканских странах, где низкий уровень жизни, недостаток питания, ослабление организма, чаще болеют дети.
- Спорадическая - может возникнуть также как очаг в любом регионе, среди малообеспеченных слоёв населения.
- Иммунодефицитная – развивается у больных СПИДом, после тяжёлых инфекций, интоксикаций, облучения, принимающих иммуносупрессоры (больных волчанкой, язвенным колитом, ревматоидным полиартритом, а также у лиц с пересаженными донорскими органами).
Стадии лимфомы Беркитта
Выделяют 4 стадии развития лимфомы Беркитта.
Стадия 1. Онкологический процесс локализован в одной области лимфатических узлов. Данная стадия заболевания длится недолго. Оно быстро переходит на следующий этап своего развития.
Стадия 2. Опухоль распространяется на близлежащие лимфоузлы, которые расположены по одну сторону с уже пораженными лимфомой лимфатическими узлами относительно диафрагмы.
Стадия 3. Поражаются лимфатические узлы по другую сторону диафрагмы.
Стадия 4. Опухолевый процесс выходит за границы лимфатической системы и распространяется на внутренние органы.
Кроме того, в ходе диагностики заболевания принято разделять патологию на категорию А или В.
- Категория А — бессимптомное течение заболевания.
- Категория В — на фоне развития лимфоопухолевого процесса возникает истощение, усиливается потоотделение, повышается температура тела.
Симптомы лимфомы Беркитта
Лимфома Беркитта отличается тяжёлым клиническим течением, которое проявляется:
- высокой температурой тела,
- интоксикацией,
- тяжёлым общим состоянием,
- отёками,
- геморрагическим синдромом (множество кровоподтёков на теле, носовые кровотечения, кровоточивость дёсен),
- быстрой потерей веса,
- нарастанием общей слабости.

Местные симптомы проявляются:
- болями в суставах,
- позвоночнике,
- в грудной клетке,
- животе,
- кашлем,
- одышкой,
- тошнотой и рвотой,
- вздутием живота,
- могут развиться параличи конечностей,
- потеря зрения при развитии очага лимфомы в области глаза.
Как проводится диагностика лимфомы Беркитта
Главным критерием в диагностике лимфомы Беркитта является исследование лимфатических узлов, крови, костного мозга и выявление специфических изменённых лимфомных клеток. Обязательным является полное томографическое исследование организма — лимфатической и костной системы, внутренних органов с помощью современных методов. Для этого выполняют:
Современное лечение лимфомы Беркитта

Программа лечения лимфомы Беркитта в Израиле включает интенсивную противоопухолевую терапию, очистку организма от токсинов, патологических опухолевых клеток, нормализацию иммунитета, свёртывающей системы и функции всех органов. Назначают интенсивный курс полихимиотерапии из нескольких препаратов, иммунотерапию, радиотерапию – облучение опухолевых очагов. Из биопрепаратов хорошо зарекомендовали себя моноклональные антитела (ритуксимаб), применяются новые целевые таргетные препараты.
Для очистки крови в специализированных отделениях проводят процедуру экстракорпоральной гемосорбции (ЭГ) по специальной программе, при которой кровь перекачивается через специальные фильтры, и очищается от злокачественных лимфоцитарных клеток. Очень эффективной является трансплантация костного мозга или стволовых клеток плацентарной (пуповинной) крови.
Химиотерапия

В основе химиотерапии — цитостатические препараты. Дополнительно назначаются иммуномодуляторы. Их сочетание подбирается в индивидуальном порядке. Учитывается форма лимфомы и ее стадия. Чтобы получить максимальный результат, лекарства вводят внутривенно или в спинной мозг (интратекальное введение). Предпочтение отдается второму способу, так как лекарственные препараты сразу попадают в спинномозговую жидкость и обеспечивают больший терапевтический эффект. Химиотерапия включает несколько курсов и может занять от двух месяцев до двух лет.
Биологическая терапия, иммунотерапия

Современная программа лечения лимфом включает применение инновационных лекарств, в основе которых заложены моноклональные антитела. Под их воздействием злокачественные клетки приобретают чувствительность к влиянию иммунитета. При иммунотерапии активизируются защитные функции иммунной системы, и опухоль уничтожается естественным образом.
Лучевая терапия
Радиотерапия дает хорошие результаты в сочетании с химиотерапией. На новообразование воздействуют высокоэнергетическими лучами. При этом здоровые клетки не затрагиваются, а злокачественные разрушаются. Использование точной аппаратуры (новейших линейных ускорителей) позволяет с идеальной точностью направлять лучи на пораженные лимфомой области — лимфатические узлы и ткани, которые их коружают.

Трансплантация костного мозга
Если заболевание перешло на поздние стадии развития, нарушены процессы образования крови и образуются метастазы в отдаленные органы, врачи прибегают к радикальному методу лечения — пересадке костного мозга или стволовых клеток. После трансплантации восстанавливаются процессы кроветворения.
Хирургическая операция

Оперативное лечение проводится лишь в случаях, когда опухолевый лимфоматозный очаг нарушает функцию органа и становится опасным. Обычно так происходит на поздней стадии лимфомы. В процессе операции хирург удаляет очаг поражения и небольшой участок прилегающей здоровой ткани.
Большой выбор современных препаратов в сочетании с другими методами, возможность индивидуального выбора оптимальной программы лечения лимфомы Беркитта в Израиле для каждого пациента даёт хорошие результаты. Длительных ремиссий заболевания израильским специалистам удаётся достичь у 80-90% пациентов.
Лимфома Беркитта у детей
Заболевание встречается как у детей, так и у взрослых. Но чаще всего от этого вида лимфомы страдают дети в возрасте от 3 до 7 лет. Нередки случаи диагностики болезни в подростковом возрасте. В 30% случаев выявляются локализации лимфомы в области, где тонкий кишечник переходит в толстый. При развитии болезни часто страдают яички, яичники , надпочечники, желудок, поджелудочная железа, челюсти, почки. Реже болезнь поражает слюнные, щитовидные и молочные железы .
Первичный очаг образуется в лимфоузлах, а затем переходит на орган, который они окружают.
Прогноз при лимфоме Беркитта

Если лечение правильно подобрано и вовремя начато, то врачи говорят о полном излечении с ремиссией больше пяти лет. Благоприятные прогнозы даются и в случае удачной трансплантации костного мозга.
На поздних стадиях прогнозы неблагоприятные, так как происходит поражение внутренних органов. В таком случае исход лечения будет зависеть от результатов сопроводительной терапии и восстановления иммунных функций пациента, особенно у детей. Основная задача врачей — не допустить возникновения вторичной инфекции, так как именно она чаще всего приводит к летальному исходу.
Стоимость лечения лимфомы Беркитта

Современные средства, применяемые при лечении лимфомы Беркитта за границей, являются дорогостоящими, да и сам курс лечения довольно продолжительный, и подбирается индивидуально в каждом конкретном случае. От этого и будет зависеть цена лечения лимфомы Беркитта. Но при аналогичных технологиях она будет различной в зависимости от страны и клиники. Лечение в Израиле всегда будет более доступным по цене, чем в западных странах.
Лимфома Беркитта — болезнь, лечение которой должно быть начато как можно скорее. Обращайтесь в нашу клинику и мы быстро подберем для Вас персональную программу эффективного лечения на основе передовых методик.
Лимфома Беркитта. Виды, симптомы, диагностика и лечение лимфомы Беркитта.
Лимфома Беркитта – это одна из форм неходжкинской лимфомы, при которой рак начинается в иммунных клетках. Лимфома Беркитта признана самой быстрорастущей опухолью у человека, и если вовремя не начать лечение, она быстро приводит к смертельному исходу. Но интенсивная химиотерапия более чем в половине случаев помогает существенно продлить жизнь пациентам с лимфомой Беркитта.
Лимфома Беркитта названа в честь британского хирурга Дениса Беркитта, который впервые диагностировал это заболевание в 1956 году среди африканских детей. В Африке лимфомой болеют дети, у которых также есть малярия и вирус Эпштейна-Барра, вызывающий инфекционный мононуклеоз. Вероятно, что малярия ослабляет реакцию иммунной системы на вирус Эпштейна-Барра, и это позволяет ему влиять на зараженные клетки, превращая их в раковые.
За пределами Африки лимфома Беркитта встречается редко. К появлению этого заболевания более склонны люди, инфицированные ВИЧ – вирусом иммунодефицита человека. По статистике, заболеваемость лимфомой Беркитта у ВИЧ-положительных людей в 1000 раз выше, чем у тех, кто не инфицирован.
Типы лимфомы Беркитта
В классификации Всемирной организации здравоохранения выделены три типа лимфомы Беркитта:
- Эндемическая (африканская лимфома), о которой мы рассказали выше;
- Спорадическая лимфома Беркитта. Эта форма лимфомы встречается во всем мире. По статистике, на долю спорадической лимфомы Беркитта приходится от 1 до 2% всех случаев лимфомы у взрослого населения.
- Лимфома, связанная с иммунодефицитом. Этот тип лимфомы Беркитта чаще всего встречается у людей с ВИЧ/СПИДом. Но может развиться и у людей с врожденными условиями, вызывающими иммунодефицит, а также у пациентов, перенесших пересадку органов и принимающих иммуносупрессивные препараты (подавляющие иммунную систему).
2. Симптомы лимфомы Беркитта
Симптомы лимфомы Беркитта зависят от ее типа. Эндемическая (африканская) лимфома обычно начинается с опухоли челюсти или других лицевых костей. Кроме того, она может влиять на желудочно-кишечный тракт, грудь и яичники, а также распространяться на центральную нервную систему, вызывая повреждение нервов, слабость и паралич.
Спорадическая и иммунодефицитная лимфомы Беркитта обычно начинаются в кишечнике и образуют большие опухоли в брюшной полости. Позже зачастую поражается печень, селезенка и костный мозг. Рост раковых клеток при лимфоме Беркитта может начаться и в яичниках, яичках или других органах, распространяясь на мозг и спинномозговую жидкость.
Помимо роста опухоли симптомами лимфомы Беркитта могут быть:
- Потеря аппетита;
- Потеря веса;
- Усталость;
- Потоотделение по ночам;
- Необъяснимое повышение температуры.
3. Диагностика лимфомы Беркитта
Поскольку лимфома Беркитта распространяется очень быстро, ранняя диагностика имеет решающее значение для выздоровления пациента.
При подозрении на лимфому Беркитта проводится биопсия увеличенных лимфатических узлов или других предполгагаемых очагов заболевания. Взятие образца ткани и его дальнейшее исследование под микроскопом помогут подтвердить или исключить диагноз лимофма Беркитта.
Дополнительными методами диагностики лимфомы могут быть:
- Компьютерная томография грудной клетки, живота и таза;
- Рентгенограмма грудной клетки;
- ПЭТ, или позитронно-эмиссионная томография;
- Биопсия костного мозга;
- Исследование спинномозговой жидкости;
- Анализы крови для оценки работы почек и печени;
- Тестирование на ВИЧ-инфекцию.
4. Лечение лимфомы Беркитта
Интенсивная внутривенная химиотерапия, которая обычно проводится в стационаре – самый эффективный метод лечения лимфомы Беркитта. Поскольку лимфома Беркитта может распространяться на жидкости, окружающие головной и спинной мозг, химиотерапевтические препараты могут вводиться непосредственно в спинномозговую жидкость. Этот метод лечения называется интратекальная химиотерапия.
Для лечения лимфомы Беркитта могут использоваться различные препараты. Например, циклофосфамид, цитарабин, доксорубицин, этопозид, метотрексат, винкристин и другие.
Интенсивная химиотерапия может быть как самостоятельным методом лечения лимфомы Беркитта, так и составной частью сложного лечения. Наравне с химиотерапией используются:
- Ритуксимаб – моноклональное антитело, которое прилипает к белкам раковых клеток и стимулирует иммунную систему атаковать раковые клетки;
- Трансплантация аутологичных стволовых клеток. Это стволовые клетки, которые ранее были взяты у пациента и сохранены в банке стволовых клеток;
- Лучевая терапия;
- Терапия стероидами.
Лимфома Беркитта – смертельное опасное заболевание, если его не лечить. У детей своевременная интенсивная химиотерапия обычно помогает вылечить лимфому и спрогнозировать долгосрочную выживаемость в 60-90% случаев. У взрослых пациентов результаты бывают очень разными, но в среднем своевременное лечение – это долгосрочная выживаемость в 70-80% случаев, что тоже немало.
Заболевания Первичное обследование- Анализы крови на онкомаркеры
- МРТ головы, позвоночника, органов малого таза, органов брюшной полости
- МСКТ органов грудной клетки
- МСКТ органов брюшной полости (виртуальная колоноскопия)
- Гастроскопия (возможность проведения под наркозом, биопсия)
- Колоноскопия (возможность проведения под наркозом, биопсия)
- Бронхоскопия (с биопсией)
- Сцинтиграфия (костей скелета, легких)
Если вы обнаружили у себя подобные симптомы, возможно, это сигнал заболевания, поэтому рекомендуем проконсультироваться с нашим специалистом.
Диагностика- Анализы крови на онкомаркеры
- МРТ головы, позвоночника, органов малого таза, органов брюшной полости
- МСКТ органов грудной клетки
- МСКТ органов брюшной полости (виртуальная колоноскопия)
- Гастроскопия (возможность проведения под наркозом, биопсия)
- Колоноскопия (возможность проведения под наркозом, биопсия)
- Бронхоскопия (с биопсией)
- Сцинтиграфия (костей скелета, легких)
- Консультация врача онколога, профессор - 10000 р.
- Онкомаркеры:
- ПСА (простатический специфический антиген) общий - 575 р.
- ПСА общий/ПСА своб.(отношение) - 1040 р.
- РЭА (раковый эмбриональный антиген) - 730 р.
- СА 15-3 - 780 р.
- СА 19-9 - 770 р.
- СА 125 - 740 р.
- UBC (антиген рака мочевого пузыря) - 1775 р.
- СА 72-4 - 1170 р.
- Cyfra 21-1 - 1220 р.
- NSE (нейрон-специфическая енолаза) - 1550 р.
- SCC (антиген плоскоклеточной карциномы) - 1550 р.
- НЕ 4 (секреторный белок эпидидимиса 4) - 1150 р.
- СА 242 - 900 р.
- Белок S 100 - 2475 р.
- CgA (хромогранин А) - 2490 р.
- МРТ (головы, позвоночника, органов малого таза. органов брюшной полости) один отдел на базе ЛПУ-партнера - от 6000 р.
- МСКТ органов грудной клетки на базе ЛПУ-партнера - от 6000 р.
- Гастроскопия (ЭГДС, эзофаго-гастро-дуоденоскопия) на базе ЛПУ-партнера без наркоза/с наркозом (во сне) - от 6000/10000 р.
- Колоноскопия на базе ЛПУ-партнера без наркоза/с наркозом (во сне) - от 12000/20000 р.
- ПЭТ-КТ на базе ЛПУ-партнера - от 35000 р.
- Сцинтиграфия костей скелета на базе ЛПУ-партнера - от 8000 р.
Мы стараемся оперативно обновлять данные по ценам, но, во избежание недоразумений, просьба уточнять цены в клинике.
Данный прайс-лист не является офертой. Медицинские услуги предоставляются на основании договора.
Читайте также:
